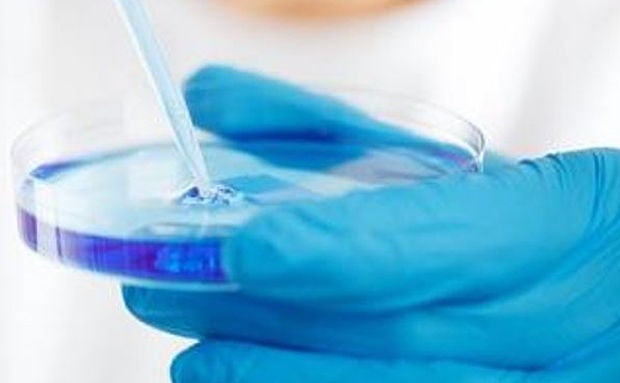

Providing process solutions to decarbonize and reduce the environmental impact of water and energy resources
Bio Business

Contributing to the realization of a sustainable society by the development of cell culture equipment that meets customer needs with the use of fluid and thermal control technology
Cell agriculture, including cultured meat, is attracting attention as foodtech to solve the food crisis attributable to the impending population explosion and climate change. Structural proteins produced by fermentation are expected to be used as new materials that do not rely on conventional petroleum products.The control of fluids, such as culture medium, oxygen, and carbon dioxide, and temperature control are important processes for cell cultures, which are a common element to both cultured meat and structural proteins. We are utilizing the engineering that EBARA CORPORATION has cultivated since its foundation to realize a highly efficient and high-quality cell culture process.
Social issues and EBARA’s solutions




Cultured meat manufacturing process